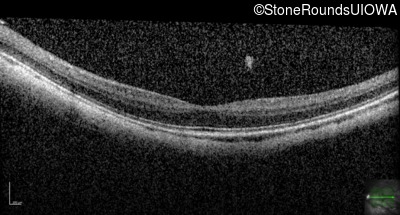
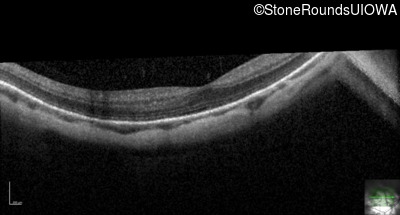
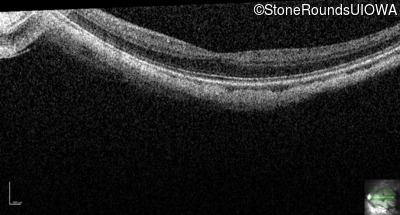

Case
SR671
Student Mode
XL Congenital Stationary Night Blindness (IA2fi)
Male
Male
Hidden
SR671
Student Mode
XL Congenital Stationary Night Blindness (IA2fi)
Male
Male
History
This 25 year old man had pronounced esotropia noticed at six months of age. As a toddler, his parents noticed that he could not see well in dim light.
| Age at visit: 25 years |
Diagnosis & molecular findings
| Disease | Gene | Allele 1 variant(s) | Allele 2 variant(s) | Inheritance mode |
|---|---|---|---|---|
| XL Congenital Stationary Night Blindness | NYX | Leu307Arg CTG>CGG | XL |
Gene:
Allele 1:
Leu307Arg CTG>CGG
Allele 2:
Inheritance:
XL